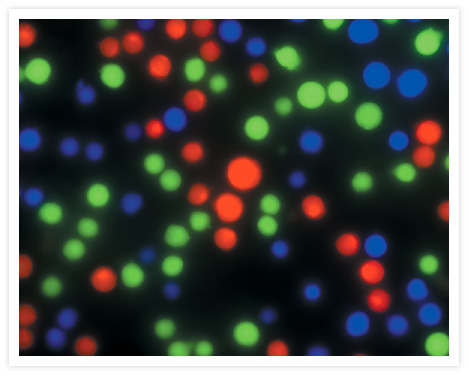

Search
Search
Jurkat cells were incubated with either green-fluorescent calcein AM (C1430, C3099, C3100MP), CellTrace™ calcein red-orange AM (C34851) or calcein blue AM (C1429). The labeled cells were then combined and imaged with the appropriate filters.
Cyanobacteria. BODIPY® FL, DAPI and CellTracker™ Green BODIPY®. Go ›
Brain of a zebrafish embryo. CellTracker CM-DiI. Go ›
BPAE cells fixed and permeabilized using the Image-iT® Fixation/Permeabilization Kit. Go ›
BPAE cells fixed and permeabilized using the Image-iT® Fixation/Permeabilization Kit. Go ›
Live cell imaging with CellLight™ reagents. Go ›
Live cells transduced with Organelle Lights™ or Cellular Lights™ reagents. Go ›
CD335 (NKp46) Antibody (63335182) in RE Go ›
CD223 (LAG-3) Antibody (56223942) in TM Go ›